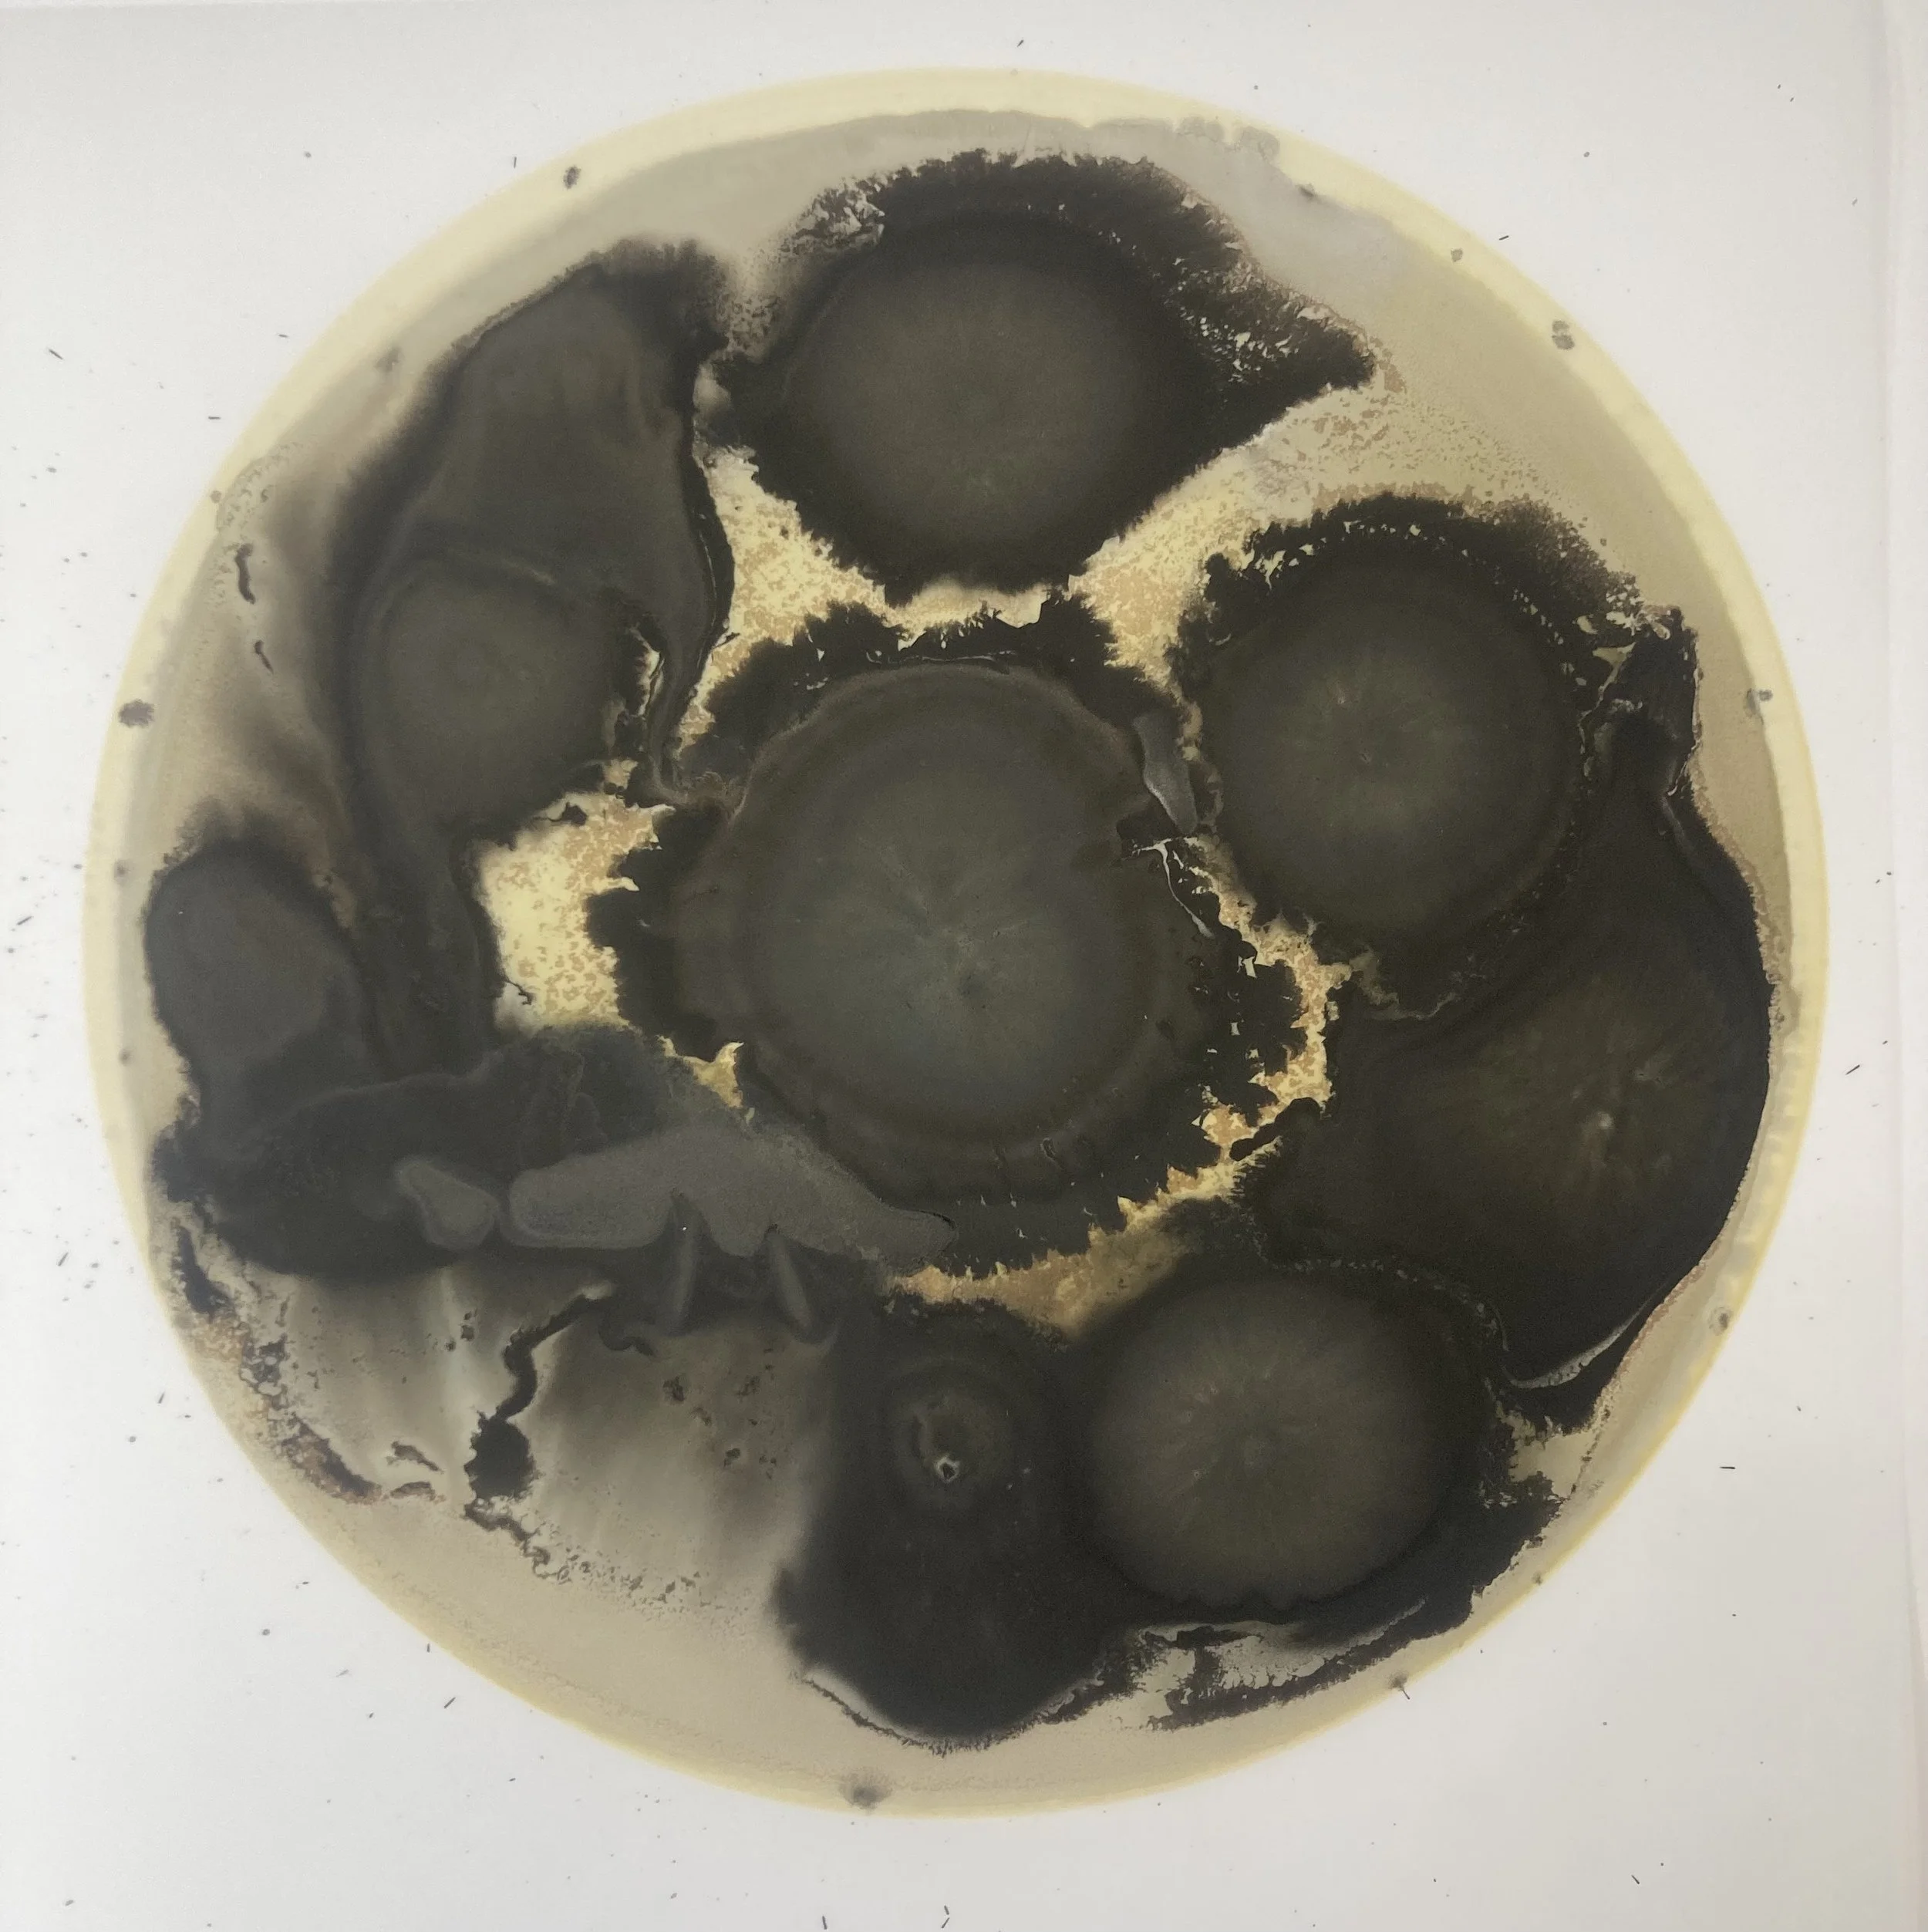

tt-12-24-6
$650.00
2024
12" x 12"
Ink on frosted mylar (framed)
*Seller will contact Buyer directly after point of sale to determine Shipping and Handling.
Add To Cart
2024
12" x 12"
Ink on frosted mylar (framed)
*Seller will contact Buyer directly after point of sale to determine Shipping and Handling.
2024
12" x 12"
Ink on frosted mylar (framed)
*Seller will contact Buyer directly after point of sale to determine Shipping and Handling.